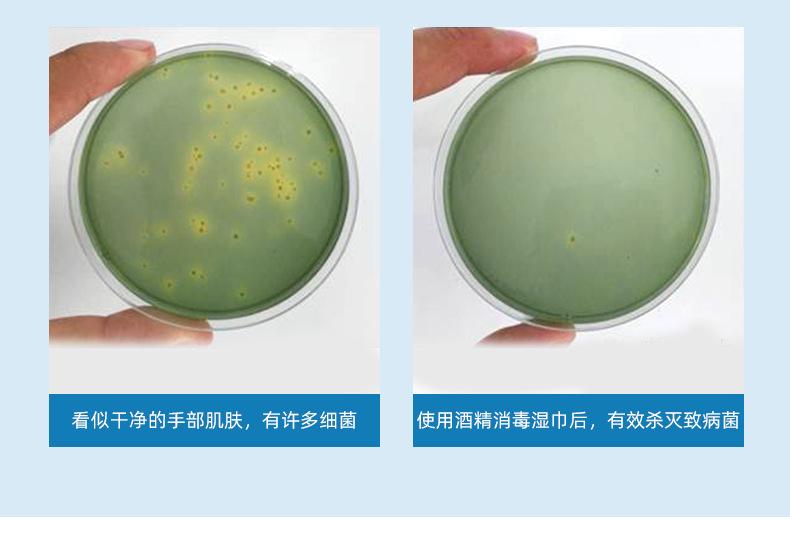
酒精小包_04.jpg

| Armazene recomendações de vendas interessantes |
-
 Pacote extra grande de panos de cozinhaPreço chocante¥0,45Comprar agora
Pacote extra grande de panos de cozinhaPreço chocante¥0,45Comprar agora -
 Papel higiênico lavável, papel de polpa de madeiraPreço chocante¥1,49Comprar agora
Papel higiênico lavável, papel de polpa de madeiraPreço chocante¥1,49Comprar agora -
 Um pedaço de lenço umedecido para mãos e bocaPreço chocante¥0,38Comprar agora
Um pedaço de lenço umedecido para mãos e bocaPreço chocante¥0,38Comprar agora -
 Lenços umedecidos com álcool 75%Preço chocante¥2,37Comprar agora
Lenços umedecidos com álcool 75%Preço chocante¥2,37Comprar agora -
 Toalhetes de limpeza de carroPreço chocante¥1,9Comprar agora
Toalhetes de limpeza de carroPreço chocante¥1,9Comprar agora -
 A popular caneta removedora de manchas de DouyinPreço chocante¥1,8Comprar agora
A popular caneta removedora de manchas de DouyinPreço chocante¥1,8Comprar agora -
 Spray de álcool 75%Preço chocante¥1,6Comprar agora
Spray de álcool 75%Preço chocante¥1,6Comprar agora -
 Um pedaço de lenços de cozinha com frete grátisPreço chocante¥6,8Comprar agora
Um pedaço de lenços de cozinha com frete grátisPreço chocante¥6,8Comprar agora -
 Lenços umedecidos populares para jaquetasPreço chocante¥0,5Comprar agora
Lenços umedecidos populares para jaquetasPreço chocante¥0,5Comprar agora -
 Lenços umedecidos para celebridades da internet, 30 unidadesPreço chocante¥0,5Comprar agora
Lenços umedecidos para celebridades da internet, 30 unidadesPreço chocante¥0,5Comprar agora -
 75 lenços desinfetantes 80 peçasPreço chocante¥0,55Comprar agora
75 lenços desinfetantes 80 peçasPreço chocante¥0,55Comprar agora -
 75 lenços umedecidos com álcool 12 peçasPreço chocante¥0,9Comprar agora
75 lenços umedecidos com álcool 12 peçasPreço chocante¥0,9Comprar agora -
 Toalhetes de cozinha Big MacPreço chocante¥0,54Comprar agora
Toalhetes de cozinha Big MacPreço chocante¥0,54Comprar agora -
 75 toalhetes desinfetantes com álcool 10 peçasPreço chocante¥0,34Comprar agora
75 toalhetes desinfetantes com álcool 10 peçasPreço chocante¥0,34Comprar agora -
 plástico bolha para lavanderiaPreço chocante¥2,8Comprar agora
plástico bolha para lavanderiaPreço chocante¥2,8Comprar agora -
 Processamento e personalização de lenços para limpeza de jaquetasPreço chocante¥0,54Comprar agora
Processamento e personalização de lenços para limpeza de jaquetasPreço chocante¥0,54Comprar agora
 |
||
 |
 |
 |
 |
 |
 |
 |
 |
 |
É mais adequado para uso como pequenos presentes para lojas maternas e infantis, lojas Taobao e distribuição de presentes AB. Após solicitar a distribuição, você pode fazer um pedido de distribuição e enviar formulários em grandes quantidades.Estoque suficiente, prazo de entrega garantido. É mais econômico comprar na caixa.(Para obter detalhes, consulte o atendimento ao cliente on-line)
-------------------------------------------------- ---------
Marca: Mian'erbao
O modelo universal acabado está em estoque conforme mostrado na imagem e pode ser encomendado diretamente.
O material deste produto é tecido não tecido spunlace, não tecido não tecido de poliéster de baixa qualidade!
[Se precisar de personalização, entre em contato com o atendimento ao cliente online]
Peso do produto: cerca de 62g por pacote
(É normal que o peso da umidade de diferentes lotes de produtos varie ligeiramente e esteja dentro da faixa padrão nacional)
Tamanho dos lenços umedecidos: 15*20 CM
Quantidade de embalagem: 300 pacotes/caixa
Padrão de implementação: GB 15979-2002
Licença de saúde: Licença de Saúde e Saúde de Zhejiang (2018) No.
-------------------------------------------------- -----------